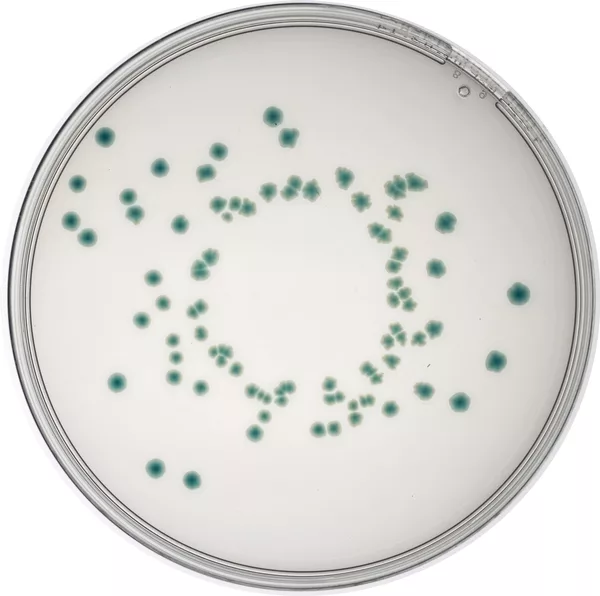

Lab M Adds Cronobacter sakazakii Isolation Medium to Pinnacle™ Poured Plates Range
Lab M’s fast-establishing range of Pinnacle™ pre-prepared agar plates now includes Cronobacter sakazakii Isolation Medium (CSIM) for added convenience when testing infant milk products.
Cronobacter sakazakii (formerly known as Enterobacter sakazakii) is a member of the Enterobacteriaceae family and has been associated with serious outbreak infections in neonates (premature infants) fed on infant formula milk. Pinnacle™ CSIM uses Lab M’s established Harlequin™ CSIM (ISO). This media formulation is currently recommended as part of the protocol under ISO/TS 22964:2006(E) for the isolation of Enterobacter sakazakii from milk and milk products.
Although C. sakazakii rarely causes infections in immunocompetent adults, it has been implicated in sepsis, meningitis and necrotising enterocolitis in neonates. An opportunistic pathogen, C. sakazakii is common in the environment and its ability to survive desiccation presents a significant risk for post-pasteurisation contamination and survival in spray dried milk products.
C. sakazakii appears to constitutively express high levels of α-glucosidase. This enzyme hydrolyses the chromogenic substrate 5-bromo-4-chloro-3-indolyl-α-D-glucopyranoside present in the medium, producing green to blue-green coloured colonies. Other Enterobacteriaceae such as E. coli do not express strong α-glucosidase activity and appear colourless or purple due to the uptake of crystal violet.
The combination of sodium desoxycholate, crystal violet and elevated incubation temperature produce a very selective and specific medium. Non-Enterobacteriaceae may appear colourless or violet (due to their inability to hydrolyze the chromogenic substrate) or are inhibited by the selective components and incubation temperature.
Lab M | +44 (0)161 820 3833 | LabM.com/Pinnacle
Looking for quick answers on food safety topics?
Try Ask FSM, our new smart AI search tool.
Ask FSM →








